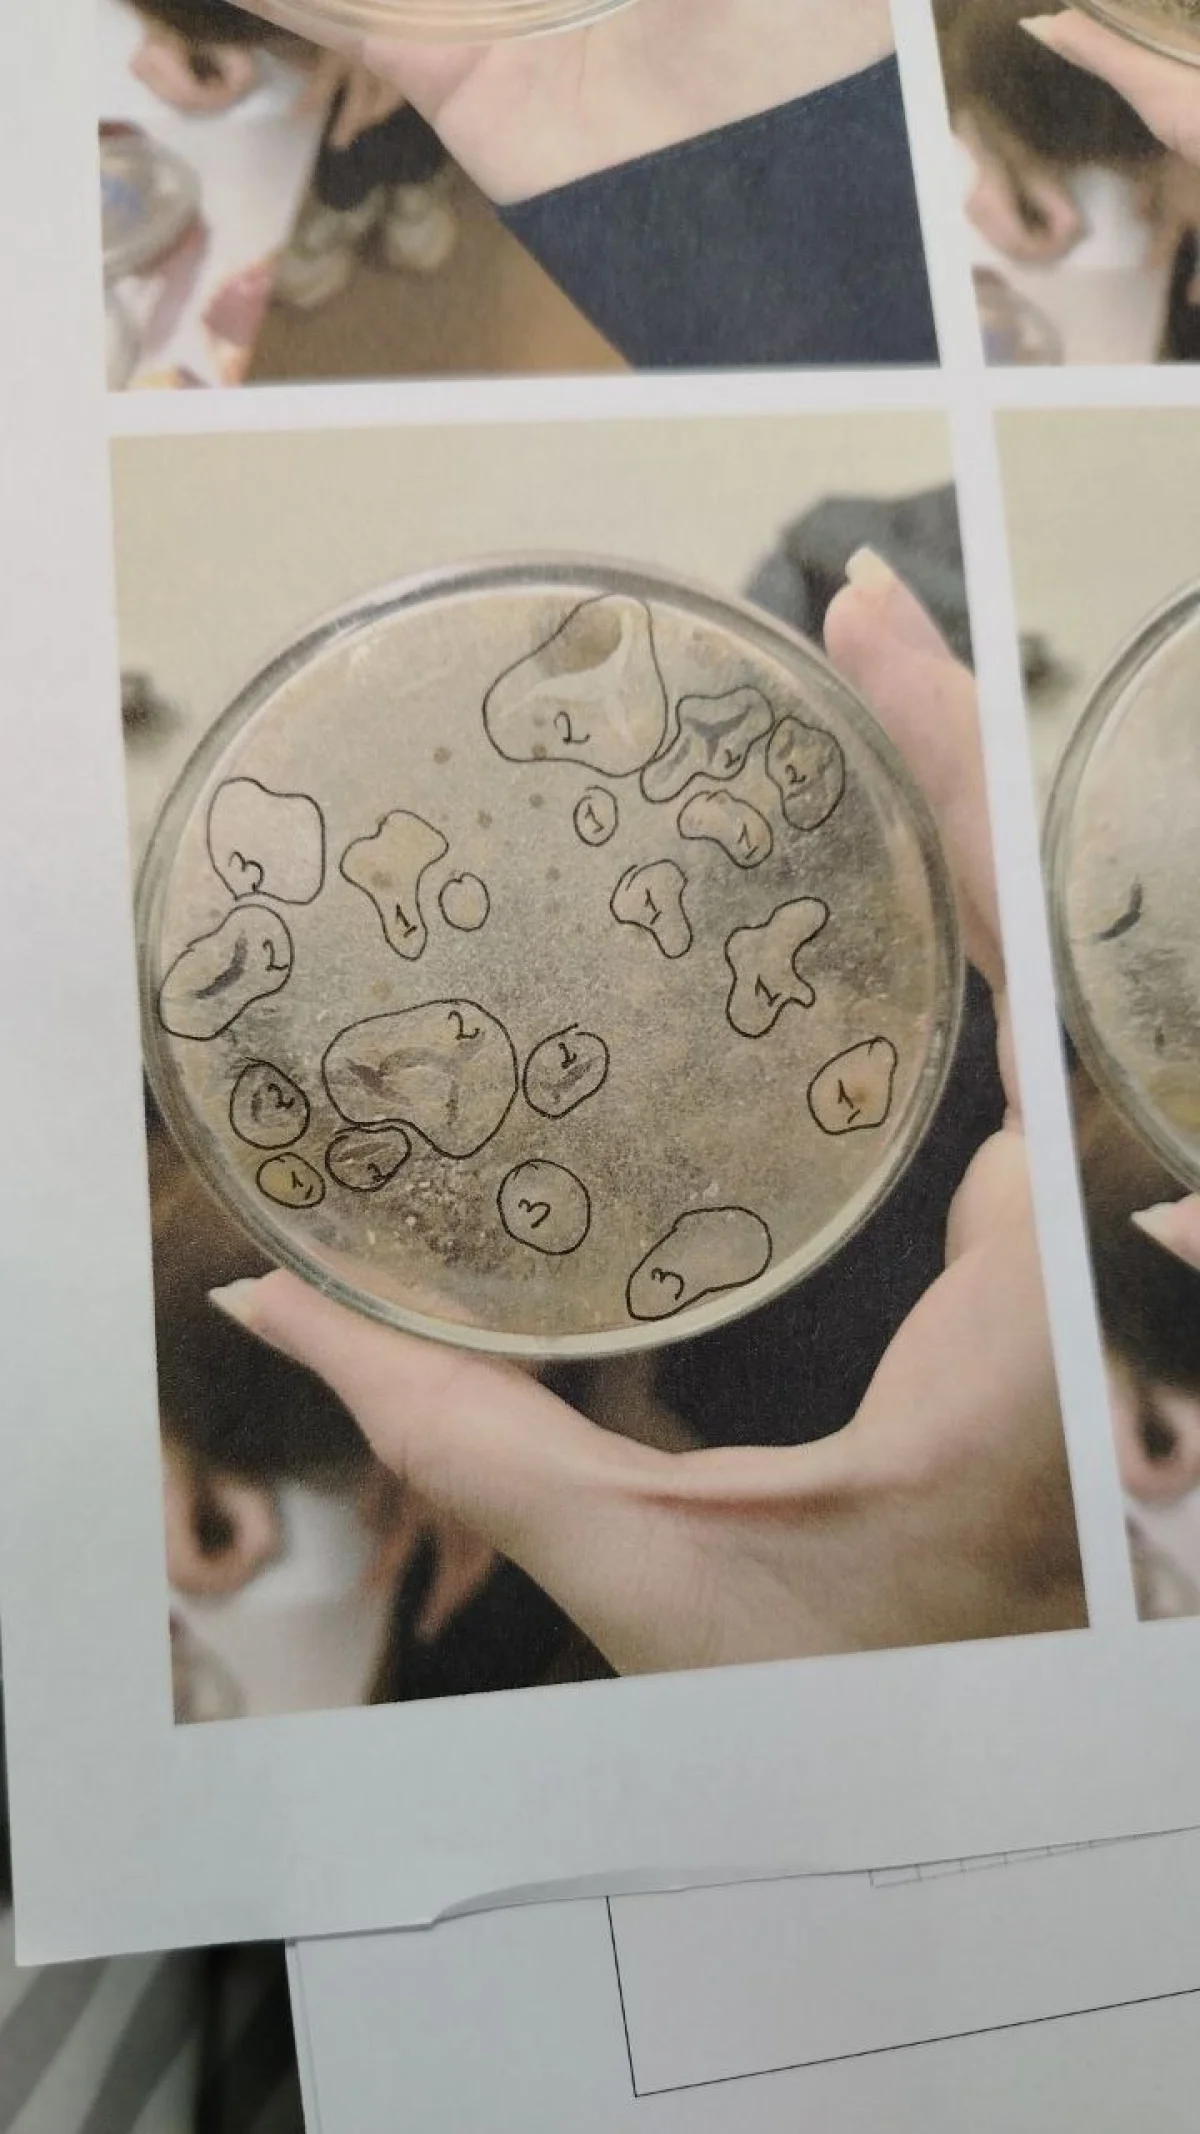

Наука в чашке Петри: как калужские школьники помогают российским ученым
Научные чтения памяти Чижевского, прошедшие недавно в Калуге, собрали ученых и исследователей.
Среди них была Ольга Андрейчук, учитель биологии и химии калужской школы №7.
Она поделилась, как им с учениками удается делать настоящие открытия прямо в классе.
Мы заинтересовываем наших детишек, чтобы они начали увлекаться наукой и практическими навыками исследовательских работ.
Ольга пояснила, что сейчас проектная и исследовательская деятельность выделена отдельный документ. Но как на деле разбудить в ребенке живой интерес?
- Приходится основываться на своих знаниях, полученном опыте, который передали нам преподаватели в школе и в университете, – говорит педагог.
– Привлекаем к сотрудничеству не только других учителей, но и родителей и даже учёных из научных институтов.
Не помешала даже разница во времени
Три года ученики Ольги Андрейчук участвуют в отборочном этапе всероссийского проекта новосибирского Института химической биологии и фундаментальной медицины Северного отделения Российской академии наук.
Им поставили конкретную научную задачу, предоставили набор лабораторного оборудования и методику, чтобы они смогли вырастить бактерии.


- Работа была связана с тем, что мы искали микроорганизмы, которые способны увеличить продуктивность кормовых культур для сельскохозяйственных животных, - объяснила Ольга. – Микроорганизмы мы искали в самых разных местах, не поверите, даже на свалке!
Также брали пробы в почве, на растительных остатках.
Сначала мы их выделили, затем посадили на подготовленную питательную среду, выращивали, наблюдали за ростом, устанавливали разные виды, делали микропрепараты, фотографировали.
В своей презентации ребята пишут:
«Мы хотели найти бактерии-пребиотики для крупного рогатого скота, способные быстро разлагать растительные остатки в компосте, а также изучить, какие элементы космической погоды влияют на рост штаммов…
Как объект исследования мы выбрали различные среды: почву, очистки картофеля, тыквы и кабачка, ботву моркови, так как в них содержатся полезные вещества…»
- На протяжении всего с эксперимента с нами на связи были новосибирские ученые, можно было через интернет задать им вопросы, - продолжает Ольга Юрьевна. - И дети с таким удовольствием общались с ними, не помеха даже то, что у нас разница во времени с Новосибирском.
Ребята отправляли ученым фотографии, получали консультации.
Причём, если дети предполагали, допустим, что это азотофиксирующие бактерии, учёные нас поправляли, говорили, что это особый вид грибов, который вырос на питательной среде.
Всё это мы забивали в базу данных, где проходила оценка и коррекция показателей.


Причастны к научным исследованиям
Работа над проектом шла в течение трёх месяцев, потому что питательная среда, на которой росли бактерии, очень быстро высыхала, хотя ее и увлажняли.
В группе было 15 человек, это условие Новосибирска. У каждого ученика - своя задача.
Один исследовал почву, другой – картофельные очистки, третий - содержимое компостной ямы, куда складывались растительные остатки сельскохозяйственного оборота предприятия.
- Самое интересное, что нигде не повторился уникальный набор штаммов, – поясняет педагог. – В каждом образце свой набор оказался.
И когда уже пересаживали на планшет в питательную среду, мы наблюдали интересные вещи: казалось бы, образцы разные, а ведут они себя очень похоже.
Вырастили микроскопические колонии. Были молочнокислые, азотофиксирующие бактерии, плесневые грибы.
Причём микропрепараты азотофиксирующих бактерий при окрашивании очень чётко давали картину, то есть мы могли пронаблюдать, в какой стороне они находятся, либо уже с образованием флоры, либо они только начинают делиться.
Школьники учились не только смотреть в микроскоп, но и систематизировать увиденное. Они заполняли настоящие научные таблицы: записывали цвет колонии, ее форму, степень разрастания.
- То есть мы учили детей не только работать с микроорганизмами, но и с первичными данными, которые можно получить при визуальном исследовании полученных образцов, - замечает Ольга. - Дети смогли не только теоретически всё изучить по научной литературе, но и практически это вырастить.
Все этапы работ они проходили самостоятельно.
Интересующие нас образцы мы помещали в специальные транспортировочные пластиковые пробирочки, запечатывали их воском и отправляли в Новосибирск.
Об этом нас просили учёные, чтобы у них была возможность изучить эти образцы у себя в лаборатории и использовать для программы, которую заказало Министерство сельского хозяйства Российской Федерации.
Дети чувствуют себя причастными к таким большим научным исследованиям, что очень важно.
Опыт с поиском микроорганизмов для сельского хозяйства у нас был не первым.
Предыдущий проект, который мы выполняли также с почвенными микроорганизмами, был направлен на то, чтобы найти новые антибиотики.
Вы знаете, сейчас большая проблема в том, что у людей сформировалась устойчивая микрофлора, которая уже не поддаётся известным антибиотикам.
Вот наши ученики искали микроорганизмы, на основе которых получили новые лекарственные препараты. Это ляжет в основу лекарств будущего!

О влиянии бытовых приборов
В своем эксперименте калужские школьники следовали протоколу новосибирского института. Но на этом не остановились.
- После того, как мы получили штаммы микроорганизмов, фантазия детей безгранична, они решили выяснить, каким же образом на их рост влияет солнечный свет, температура, рентгеновское излучение, - рассказывает Ольга Юрьевна.
Юным исследователям разрешили поставить чашки Петри в рентген-кабинете поликлиники, чтобы проверить, как облучение скажется на росте колоний.
- Дети были сильно удивлены после того, как микроорганизмы начали активно расти. Для них это было своего рода научное открытие.
Бурный рост колоний мы пронаблюдали по сравнению с контрольными чашками Петри. И предположили, что это связано с облучением.
Проверили и влияние электромагнитного излучения, бытовых приборов.
- В нашей школе есть место, где учителя могут перекусить. Там находится микроволновка, небольшой холодильник, чайник. Мы решили посмотреть, каким же образом будет излучение от них влияет на рост бактерий.
Ставили чашки Петри снаружи от микроволновки, но не увидели никаких существенных изменений.
С начальной школы
Вся эта научная деятельность происходит не в суперсовременном лабораторном комплексе, а в обычном школьном кабинете, где работает Ольга.
- Я открыла в школе, можно сказать, биолабораторию. Все это ребята изучают для расширения своего кругозора, - рассказала педагог. - Приглашаю к себе не только детей с пятого-шестого класса, но и начальную школу.
Мы изучаем хлеб, сыр, творог, молоко, то, с чем ребёнок сталкивается дома каждый день.
Может быть, какие-то современные школы могут похвастаться новейшим оборудованием.
У меня, к сожалению, пока такого оборудования нет, минимальный набор. Работаю с тем, что есть под рукой, то, что я могу купить сама. Мы садимся все вместе и начинаем исследовать.
Главный секрет успеха, по мнению Ольги Андрейчук, заключается в искренней увлеченности самого педагога. Если учитель горит своим делом, это передается ученикам.
- Чтобы зажечь огонёк в глазах ребёнка, нужно самому этим гореть, - поделилась учительница. - Пытаешься что-то найти интересное, чтоб ребёнок к тебе пришёл.
И ты видишь, что сначала приходят два-три человека, потом их становится 10-15, а затем уже возможности кабинета не позволяют усадить всех детей.
На текущий момент у Ольги Юрьевны 46 проектов. Однако будущее исследовательской программы находится под вопросом.
– Мы хотели бы повторить исследовательскую программу, но будет ли именно эта команда или новая, сказать сложно, - призналась педагог. - Потому что сейчас профиль по химии и биологии у нас закрывается, и дети вынуждены переходить в другие учебные заведения.
Получится ли у меня вырастить из седьмого класса команду, будет зависеть от условий общеобразовательного учреждения на следующий год.




